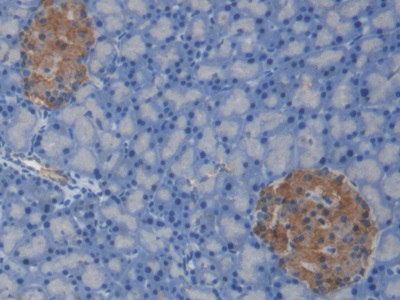

Monoclonal Antibody to C-Peptide (CP) 

Overview
Properties
- Product No.MAA447Ra23
- Organism SpeciesRattus norvegicus (Rat) Same name, Different species.
- ApplicationsIHC
If the antibody is used in flow cytometry, please check FCM antibodies.
Research use only - DownloadInstruction Manual
- CategoryEndocrinologyHormone metabolism
- SourceMonoclonal antibody preparation, Host Mouse
- Ig Isotype IgG2a Kappa, Clone Number C5
- PurificationProtein A + Protein G affinity chromatography
- LabelNone
- Immunogen CPA447Ra21-OVA Conjugated C-Peptide (CP)
- Buffer Formulation0.01M PBS, pH7.4, containing 0.05% Proclin-300, 50% glycerol.
- TraitsLiquid, Concentration 1mg/mL
Sign into your account
Share a new citation as an author
Upload your experimental result
Review

Contact us
Please fill in the blank.
Specifity
The antibody is a mouse monoclonal antibody raised against CP. It has been selected for its ability to recognize CP in immunohistochemical staining and western blotting.
Usage
Western blotting: 0.5-2µg/mL;
Immunohistochemistry: 5-20µg/mL;
Immunocytochemistry: 5-20µg/mL;
Optimal working dilutions must be determined by end user.
Storage
Store at 4°C for frequent use. Stored at -20°C in a manual defrost freezer for two year without detectable loss of activity. Avoid repeated freeze-thaw cycles.
Stability
The thermal stability is described by the loss rate. The loss rate was determined by accelerated thermal degradation test, that is, incubate the protein at 37°C for 48h, and no obvious degradation and precipitation were observed. The loss rate is less than 5% within the expiration date under appropriate storage condition.
Giveaways
Increment services
Citations
- The effect of oral and intravenous dextrose on C-peptide secretion in poniesPubmed:27065127
- Increased β-Cell Mass in Obese Rats after Gastric Bypass: A Potential Mechanism for Improving Glycemic Control.pubmed:28477035
- Urine-Based Biomarkers for Alzheimer's Disease Identified Through Coupling Computational and Experimental MethodsPubmed:30040720
- Liraglutide Combined with Human Umbilical Cord Mesenchymal Stem Cell Transplantation inhibits beta‐cells apoptosis via mediating the ASK1/JNK/BAX pathway in Pubmed: 31411368
- Liraglutide improved inflammation via mediating IL-23/Th-17 pathway in obese diabetic mice with psoriasiform skinPubmed: 31868553
- Roux-en-Y Gastric Bypass in Obese Diabetic Rats Promotes Autophagy to Improve Lipid Metabolism through mTOR/p70S6K Signaling PathwayPubmed: 32309446
- Electroacupuncture improves cognitive deficits and insulin resistance in an OLETF rat model of Al/D-gal induced aging model via the PI3K/Akt signaling pathwayPubmed: 32304687
- Discovery and validation of FBLN1 and ANT3 as potential biomarkers for early detection of cervical cancer33602229
- Different Ratios of Corn and Coconut Oil Blends in High©\Fat Diets Influence Fat Deposition without Altering Metabolic Biomarkers in Male Rats
- SARS-CoV2 Induced Biochemical Mechanisms in Liver Damage and Intestinal Lesions.